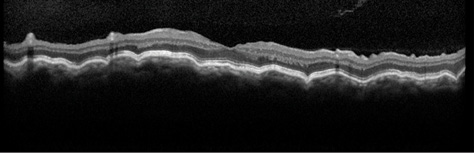

CASE PRESENTATION
A 58-year-old white woman with a history of primary open-angle glaucoma was referred to the University of Colorado Glaucoma Service in October 2014. After several years of well-controlled IOP in the midteens on daily travoprost (Travatan; Alcon) in both eyes, the pressure rose to 25 mm Hg with an occludable angle in the patient's left eye. The treating ophthalmologist performed a laser peripheral iridotomy (LPI) using a YAG laser. After the procedure, the patient's IOP was 21 mm Hg OS. Two days after the LPI, the IOP spiked to 59 mm Hg OS with a nonpatent iridotomy. After two additional attempted LPIs, the IOP remained elevated on maximally tolerated medical therapy with travoprost and a fixed combination of brinzolamide and brimonidine (Simbrinza; Alcon).
Upon examination in our clinic, the patient's UCVA was 20/20 OD and 20/25 OS. Goldmann applanation tonometry revealed an IOP of 14 mm Hg OD and 25 mm Hg OS. A 1+ afferent pupillary defect was observed on the left side. Gonioscopy showed open angles in both eyes with dense pigment in the left eye thought to be related to the recent LPI. A slit-lamp examination was remarkable for pigmented cells in the anterior chamber of the left eye as well as trace nuclear sclerotic cataracts bilaterally. The cup-to-disc ratio was 0.5 OD and 0.7 OS. The acute IOP elevation was believed to be due to pigment released after the LPI. The patient was initially observed to allow the pigment to clear and the IOP to improve. She continued administering travoprost at bedtime in both eyes and brinzolamide-brimonidine twice daily in the left eye.
Figure 1. An OCT image of the patient's left eye shows chorioretinal folds consistent with hypotony maculopathy. Visual acuity is 20/70, and the IOP measures 3 mm Hg.
When the patient followed up with her referring ophthalmologist the next day, the IOP was 43 mm Hg OS. Given her history of intolerance for b-blockers and oral acetazolamide, she was considered to be on maximal tolerated topical therapy with the current regimen. Treatment with oral methazolamide was therefore started, and the patient was scheduled for a trabeculectomy with implantation of an Ex-Press Glaucoma Filtration Device (Alcon) with intraoperative mitomycin C (MMC). During surgery, a fornix-based conjunctival flap was created, and sponges soaked in MMC 0.4 mg/mL were applied to the scleral bed for 2 minutes after the creation of the partial-thickness scleral flap. The insertion of the Ex-Press device was uneventful, and three 10–0 nylon sutures (Ethicon) were placed to secure the scleral flap. Conjunctival closure followed in a standard watertight fashion.
On postoperative day 1, the patient's visual acuity measured 20/40, and the IOP was 8 mm Hg OS with a formed Seidel-negative bleb. The patient was instructed to discontinue methazolamide and all IOP-lowering drops for the left eye, and she started using topical moxifloxacin (Vigamox; Alcon) four times daily and prednisolone acetate 1% six times daily in her left eye. The steroid was tapered gradually during the postoperative period.
In the initial postoperative months, the patient developed a low, diffuse bleb, and the IOP decreased to 3 to 4 mm Hg OS. The bleb remained Seidel negative throughout this period. By postoperative week 10, the patient's visual acuity had decreased to 20/70 OS with an IOP of 3 mm Hg. A fundus examination revealed the presence of chorioretinal folds consistent with hypotony maculopathy, and this finding was confirmed by optical coherence tomography (OCT; Figure 1). By this time, topical steroid therapy had been discontinued in an effort to promote wound healing.
HOW WOULD YOU PROCEED?
- Would you place a large-diameter bandage contact lens and observe the patient?
- Would you inject a cohesive viscoelastic in the anterior chamber to increase IOP?
- Would you place transconjunctival bleb compression sutures?
- Would you perform an open bleb revision to place additional sutures through the scleral flap?
SURGICAL COURSE
Initially, we instituted conservative therapy with topical atropine 1% four times daily and the placement of a 24-mm-diameter bandage contact lens. Our goal was to compress bleb tissues and allow scar tissue to form at the site of compression to slow aqueous outflow and increase the IOP. By postoperative week 12, however, the patient's visual acuity had decreased to 20/100, and the IOP remained 4 mm Hg OS. We decided to place transconjunctival sutures through the scleral flap in the OR. A total of five 10–0 nylon sutures were placed directly through conjunctiva and the underlying scleral flap, then into sclera and back out through conjunctiva, after which they were secured. Sutures placed in this manner have the advantage of requiring no conjunctival dissection, thereby minimizing manipulation of the existing bleb. After placement, these sutures lie on top of the bleb; with time, however, they migrate into the subconjunctival space.1,2 On postoperative day 1, the patient's visual acuity improved to 20/70, and the IOP was 10 mm Hg OS.
Unfortunately, the patient developed a bleb leak at the anterior border of the fornix-based conjunctival flap. The conjunctiva in this area was noted to be ischemic, and the leak continued despite the placement of a bandage contact lens. We scheduled an open revision of the initial surgery. During surgery, areas of ischemic conjunctiva were resected, and the posterior conjunctiva was mobilized to allow for adequate coverage up to the limbus. The previously placed sutures were noted to be loose and were removed. Five new 10–0 nylon sutures were placed to secure the scleral flap, followed by conjunctival closure in a watertight fashion.
OUTCOME
On the first postoperative day, the patient's visual acuity was 20/80, and the IOP was 14 mm Hg OS. By 1 month after the open bleb revision, the IOP had stabilized at 13 mm Hg OS, and the patient's visual acuity had improved to 20/25 OS. A slit-lamp examination was notable for a low-lying diffuse bleb without evidence of a wound leak. A fundus examination and OCT confirmed significant improvement in the patient's chorioretinal folds that was consistent with the reversal of hypotony maculopathy (Figure 2).

Figure 2. An OCT image of the patient's left eye after the second bleb revision shows significant improvement in the previously noted chorioretinal folds. Visual acuity is 20/25, and the IOP measures 13 mm Hg.
DISCUSSION
Hypotony (typically defined as an IOP ≤ 5 mm Hg) is a known complication associated with glaucoma filtration procedures. The risk of hypotony after trabeculectomy is elevated in young and myopic patients3 as well as with the intraoperative use of antifibrotics such as MMC.4 Common causes of postoperative hypotony are wound leaks and overfiltration. Other potential etiologies include aqueous hyposecretion due to ciliary body shutdown (often related to inflammation), the formation of a cyclodialysis cleft, and retinal detachment. The management of postoperative hypotony varies depending on its cause and the impact on the patient's visual acuity and ocular anatomy.
Hypotony associated with a flat anterior chamber due to a leak or overfiltration can be addressed in the office by reforming the anterior chamber with a cohesive viscoelastic to stabilize the eye and potentially slow aqueous flow through the surgical site. If the anterior chamber is formed, more conservative treatment may be warranted. The use of a large-diameter bandage contact lens may compress an overfiltering bleb, leading to scar formation and elevating IOP. This approach can also allow a slow bleb leak to heal, thereby resolving the hypotony. Decreasing or discontinuing the use of topical steroids may permit natural wound-healing mechanisms to slow the outflow of aqueous. This should be balanced with a need to control inflammation and prevent excessive scarring, resulting in bleb failure.
Chorioretinal folds due to hypotony can become fixed, permanently limiting vision despite a resolution of hypotony. It is often taught that a longer duration of hypotony increases the risk of permanent vision loss, but some surgeons have noted no correlation between the duration of hypotony and the visual outcome.5 Indeed, dramatic visual improvement has been noted after the reversal of hypotony that was present for more than 5 years.6,7 Surgical options to treat hypotony include the placement of transconjunctival scleral flap sutures8 or conjunctival compression sutures.9
Our patient had a deep anterior chamber throughout her course, allowing for the institution of conservative measures initially. Despite these treatments, surgical intervention was ultimately required. The new onset of a bleb leak after the initial placement of transconjunctival scleral flap sutures prompted an open bleb revision with excision of ischemic bleb tissue and the advancement of healthy conjunctiva. Although invasive, this technique allowed for direct visualization of the tissue and helped us to achieve the desired result. n
Malik Y. Kahook, MD, is the Slater family endowed chair in ophthalmology; vice chair, clinical and translational research; and director, Glaucoma Service and Glaucoma Fellowship, for the Department of Ophthalmology at the University of Colorado School of Medicine in Aurora. He acknowledged unrelated research support from Alcon. Dr. Kahook may be reached at
malik.kahook@ucdenver.edu.
Leonard K. Seibold, MD, is an assistant professor of ophthalmology at the University of Colorado School of Medicine in Aurora. He acknowledged unrelated research support from Alcon. Dr. Seibold may be reached at leonard.seibold@ucdenver.edu.
Jeffrey R. SooHoo, MD, is an assistant professor of ophthalmology at the University of Colorado School of Medicine in Aurora. He acknowledged unrelated research support from Alcon. Dr. SooHoo may be reached at jeffrey.soohoo@ucdenver.edu.
1. Shirato S, Maruyama K, Haneda M. Resuturing the scleral flap through conjunctiva for treatment of excess filtration. Am J Ophthalmol. 2004;137(1):173-174.
2. Maruyama K, Shirato S. Efficacy and safety of transconjunctival scleral flap resuturing for hypotony after glaucoma filtering surgery. Graefes Arch Clin Exp Ophthalmol. 2008;246(12):1751-1756.
3. Fannin LA, Schiffman JC, Budenz DL. Risk factors for hypotony maculopathy. Ophthalmology. 2003;110(6):1185-1191.
4. Bindlish R, Condon GP, Schlosser JD, et al. Efficacy and safety of mitomycin-C in primary trabeculectomy: five-year follow-up. Ophthalmology. 2002;109(7):1336-1341; discussion 1341-1332.
5. Bashford KP, Shafranov G, Shields MB. Bleb revision for hypotony maculopathy after trabeculectomy. J Glaucoma. 2004;13(3):256-260.
6. Delgado MF, Daniels S, Pascal S, Dickens CJ. Hypotony maculopathy: improvement of visual acuity after 7 years. Am J Ophthalmol. 2001;132(6):931-933.
7. Oyakhire JO, Moroi SE. Clinical and anatomical reversal of long-term hypotony maculopathy. Am J Ophthalmol. 2004;137(5):953-955.
8. Richman J, Moster MR, Myeni T, Trubnik V. A prospective study of consecutive patients undergoing full-thickness conjunctival/scleral hypotony sutures for clinical ocular hypotony. J Glaucoma. 2014;23(5):326-328.
9. Quaranta L, Riva I, Floriani IC. Outcomes of conjunctival compression sutures for hypotony after glaucoma filtering surgery. Eur J Ophthalmol. 2013;23(4):593-596.
